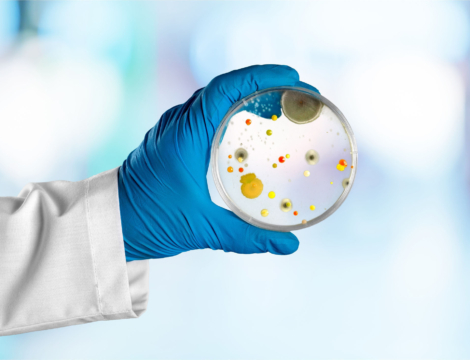
Les probiotiques pourraient-ils aider à limiter les phénomènes d’antibiorésistance ?

Santé naturelle - page 2



Publicité


Publicité
Publicité
- Comptoir officinal : optimiser l’espace sans sacrifier la relation patient
- Reishi, shiitaké, maitaké : la poussée des champignons médicinaux
- Budget de la sécu 2026 : quelles mesures concernent les pharmaciens ?
- Cancers féminins : des voies de traitements prometteuses
- Vitamine A Blache 15 000 UI/g : un remplaçant pour Vitamine A Dulcis